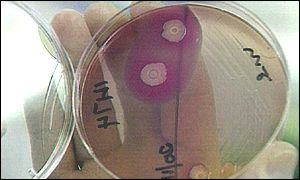
E. coli

| You are in: Health | |||||||||||||||||||||||||||||||||||||||||||||||||||||||||||||||||||||||||||||||||||||||||||||||||||||||||||||||||||||||||||||||||||||||||||
| Thursday, 1 August, 2002, 13:09 GMT 14:09 UK Go-ahead for GM diarrhoea vaccine tests E. coli causes diarrhoea An anti-diarrhoea vaccine containing a genetically modified bacterium is to be tested on human volunteers. The UK Department for the Environment, Food and Rural Affairs has given the go-ahead for limited clinical trials after being advised that the use of GM material presented a very low risk to the environment. The prototype vaccine has been developed by the British bio-tech company Acambis. It is hoped that it will eventually lead to a vaccine which could save thousands of lives in the developing world - and prevent people falling ill on holiday. The vaccine is based on a form of the E. coli bacterium, which is known to cause about 40% of cases of travellers' diarrhoea. The bug has been weakened by removing part of its genetic material. This reduces its ability to cause illness, but not to trigger a response by the immune system. US experience A similar prototype vaccine has already been through comparable clinical trials in the United States. The clinical trials will take place at Barts and The London NHS Trust. Although the volunteers will excrete the vaccine in their faeces, it will be destroyed by the sewage treatment system. In addition, further genes have been inactivated so that the organisms are less able to colonise the gut and survive in nature. However, Becky Price, from the pressure group GeneWatch, said there was evidence that another form of supposedly disabled E. coli could survive in sewage systems. She said better systems were required to monitor the impact of GM organisms in the environment. Diarrhoea is a major cause of death and serious illness in developing countries. Acambis estimates that a vaccine could potentially save the lives of 500,000 children a year in the developing world. It also envisages that it could be available as a pre-holiday jab for holidaymakers, possibly topped up once a year. However, even if the trials prove to be successful, it is not anticipated that a vaccine will be commercially available until 2008 at the earliest. | See also: 04 Jul 02 | Business 18 May 02 | South Asia 23 Jul 99 | Health Internet links: The BBC is not responsible for the content of external internet sites Top Health stories now: Links to more Health stories are at the foot of the page. | |||||||||||||||||||||||||||||||||||||||||||||||||||||||||||||||||||||||||||||||||||||||||||||||||||||||||||||||||||||||||||||||||||||||||
Links to more Health stories |
 | ||
| ---------------------------------------------------------------------------------- To BBC Sport>> | To BBC Weather>> | To BBC World Service>> ---------------------------------------------------------------------------------- © MMIII | News Sources | Privacy |